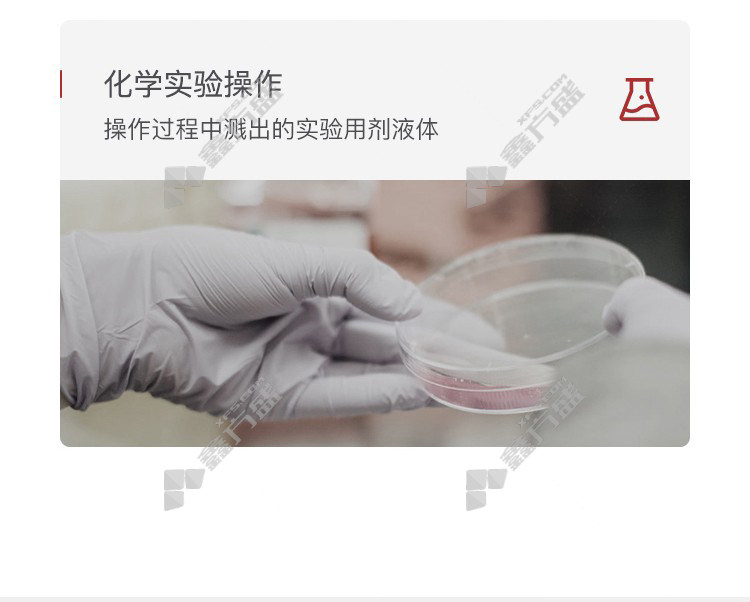

honeywell scratch-resistant goggles LG99200 LG99 scratch resistance no specification
Full-court postage
7 days no reason to return.
Quick refund
shopping cart
add to cart
Graphic details
comment(0)